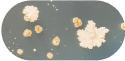

>50,000 reviews
Proven Ingredients, Clinical Results
In a double-blind, placebo-controlled human clinical study, resB® helped participants show significant improvement when taken twice daily.*
95%
participants likely to recommend resB® to others
- Clinically-studied
- Physician-formulated
- Long term benefits*
- All-natural
- Exclusive formula

72%
participants reported improvement

Forced Expiratory Volume (FEV) measures the air you can exhale from your lungs to assess lung function.
A higher than average FEV level indicates strong lung function. resB® helped increase FEV levels.*

Hear why subscribers love 

resB® Lung Support Probiotic
Clinically proven probiotic capsule loaded with potent ingredients.
Benefits*
- Respiratory structure & function support*
- May clear mucus & minimize coughing*
- Seasonal sinus & bronchial support*
- Boost immunity response*
- Improves gut & immune health*
- Better sleep due to better breathing*
Pay in 4 interest-free installments of $9.75 with Learn more




Expertly formulated routine

>50,000 five-star reviews



















Why
lung probiotic?









